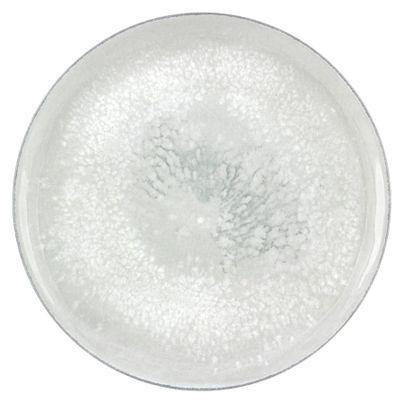

Der Smart Salt Teller coup von BAUSCHER ist die perfekte Ergänzung für deinen Tisch, wenn es um stilvolles Servieren von Salz oder anderen Gewürzen geht. Mit seiner eleganten Form und der klaren Linie passt dieser Teller nicht nur zu feierlichen Anlässen, sondern auch zu deinem täglichen Dinner. Er besteht aus hochwertigem Porzellan, das nicht nur ästhetisch ansprechend ist, sondern auch für seine Langlebigkeit bekannt ist.
Die einfache Handhabung macht diesen Teller besonders attraktiv. Fülle ihn mit deinem Lieblingssalz oder experimentiere mit verschiedenen Kräutermischungen. Der Smart Salt Teller coup ist ideal, um deinen Gästen eine Auswahl an Gewürzen zu bieten, die sie nach Belieben verwenden können. So wird jede Mahlzeit zu einem individuellen Erlebnis.
Ein weiterer Vorteil: Der Teller ist spülmaschinengeeignet. Nach dem Essen kannst du ihn mühelos reinigen, was dir Zeit und Mühe spart. Das macht ihn besonders praktisch für den täglichen Gebrauch. Du kannst ihn auch in der Mikrowelle verwenden, was dir Flexibilität bei der Zubereitung deiner Speisen gibt.
Bei der Präsentation deiner Speisen spielt der Smart Salt Teller coup eine wichtige Rolle. Platziere ihn neben deinen Hauptgerichten oder nutze ihn als Teil deines Buffet-Arrangements. Durch die schlichte Eleganz hebt er die Qualität deiner Speisen hervor und sorgt dafür, dass alles appetitlicher aussieht.
Erfahre, wie du mit diesem Teller nicht nur deine Tischkultur verbesserst, sondern auch den Geschmack deiner Gerichte unterstreichen kannst. Der Smart Salt Teller coup von BAUSCHER ist nicht nur ein nützliches Küchenutensil, sondern auch ein stilvolles Accessoire, das deinen Essbereich aufwertet.
 Versand voraussichtlich am … wenn du jetzt kaufst!
Versand voraussichtlich am 16.06.2026 wenn du jetzt kaufst!
Versand voraussichtlich am … wenn du jetzt kaufst!
Versand voraussichtlich am 16.06.2026 wenn du jetzt kaufst!